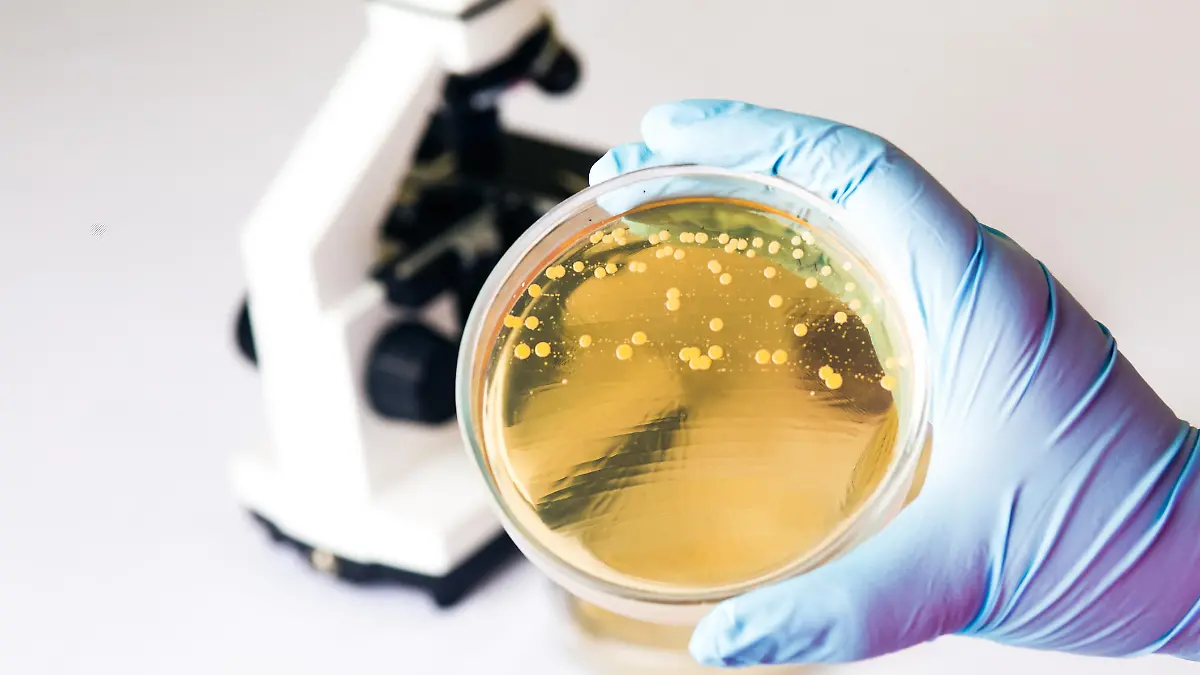

Keine Seltenheit Gesundheitslexikon: Darmpilz
Ein Darmpilz stellt für gesunde Menschen meist keine Gefahr dar. Für Personen mit einem geschwächten Immunsystem sowie für alte Menschen hingegen kann er sehr bedenklich werden.
Was ist Darmpilz?
Der Darmpilz ist ein Bestandteil der Darmflora. Er kommt dort vor, ohne dass der Mensch ihn wahrnimmt. Normalerweise verursacht er keinerlei Beschwerden. Acht von zehn Menschen tragen Pilze, meist Candida albicans, im Darm mit sich. Ein gesunder Mensch kann auch mit einer vermehrten Anzahl von Darmbakterien gut leben. Ist das Immunsystem jedoch geschwächt, kann es zu einer extremen Vermehrung der Darmbakterien kommen. Die Mikroorganismen lösen dann unter Umständen Entzündungen im Körper aus. Oft ist falsche Ernährung oder die Einnahme bestimmter Medikamente für eine vermehrte Keimbesiedelung im Darm verantwortlich. Betroffen sind häufig alte Menschen und kleine Kinder.
Ursachen: Hefepilze werden durch Milieustörungen im Magen-Darm-Trakt begünstigt
Ungesunde Ernährung kann eine Ausbreitung von Candida albicans begünstigen. Schuld hat meistens der übermäßige Zuckerkonsum in Form von Süßigkeiten sowie Softdrinks. Die zusätzliche Einnahme eines Antibiotikums verstärkt die Gefahr deutlich. Leider werden trotzdem häufig unnötigerweise Antibiotika verordnet. Auch eine Kortison-Therapie ist ein Risikofaktor. Menschen mit einem geschwächten Immunsystem sind besonders gefährdet. Dazu zählen zum Beispiel Krebspatienten oder Menschen mit Diabetes mellitus. Auch während einer hormonellen Umstellung (Schwangerschaft, Wechseljahre) ist das Risiko erhöht. Übertragen wird der Darmpilz zum Beispiel durch Küssen oder Geschlechtsverkehr, ein einfacher Händedruck reicht nicht aus.
Symptome bei einer Darmpilzerkrankung
Wenn der Darmpilz krank macht, ist fast immer ein Hefepilz die Ursache. Da er als einziger Pilz lange Zeit ohne Sauerstoff auskommt, hat er eine sehr gute Überlebenschance und kann sich daher rasch vermehren. Vom Darm aus gelangt er überall dort hin, wo es warm, feucht und nährstoffreich ist. Das kann im Magen-Darm-Bereich, in der Speiseröhre, im Mund und in der Scheide sein. Mögliche Symptome für einen Darmpilz sind:
- Völlegefühl
- Juckreiz im Intimbereich
- juckender Ausschlag am Darmausgang
- verstärkte Atemnot
- Herzschmerzen
- Gelenkschmerzen
- ständige Müdigkeit
- Heißhunger auf Süßes und kohlenhydratreiche Nahrung
- psychische Probleme
Diagnose schwer zu stellen
An der oben beschriebenen Vielzahl der Symptome wird deutlich, wie schwer es für den behandelnden Arzt ist, einen Darmpilz zu erkennen. Die Symptome sind außerdem sehr unspezifisch und können auch andere Ursachen haben. Oft ist eine aufwendige Diagnostik erforderlich. Die auslösenden Hintergründe sollten erkannt und beseitigt werden. Nur so lässt sich eine ganzheitliche Bekämpfung des Pilzes erreichen. Finden sich 100.000 koloniebildende Einheiten von Candida albicans im Stuhl des Betroffenen, sollte eine Therapie mit Pilzmittel begonnen werden.
Behandlung/Therapie bei Darmpilz
Das Wichtigste ist, den Magen-Darm-Trakt gesund zu erhalten, also wenig Zucker und Weißmehlprodukte zu sich zu nehmen, dafür viel Vollkorn und Gemüse zu essen. Viele Gewürze und Gemüsesorten enthalten natürliche antibakterielle Substanzen. Bierhefe und Hefeextrakte, die in Fertigprodukten zu finden sind, verursachen übrigens keinen Darmpilz. Auch Schimmelkäse kann unbedenklich verzehrt werden. Medikamentös behandelt man Darmpilz mit der Substanz Nystatin in Form von Tabletten, Mundspülungen oder Salben. Auch systemische Therapien mit Medikamenten, die im gesamten Körper wirken, werden eingesetzt, haben aber Nebenwirkungen.
Wichtiger Hinweis: Dieser Artikel kann einen Besuch beim Arzt nicht ersetzen. Er enthält nur allgemeine Hinweise und darf daher keinesfalls zu einer Selbstdiagnose oder Selbstbehandlung herangezogen werden.